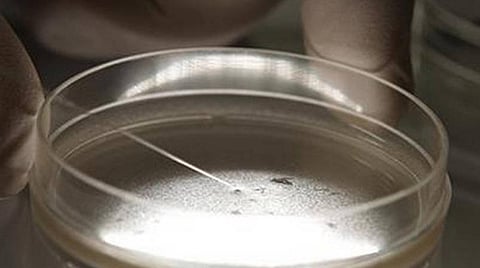
கரோனா யுத்தத்தின் ‘கேம் சேஞ்சர்’ ஆகுமா ஸ்டெம் செல் சிகிச்சை?

கடந்த நான்கு மாதங்களாக உலகம் முழுவதிலும் கோரத் தாண்டவம் ஆடி வருகிறது கரோனா. இதற்கென இன்னும் பிரத்யேக மருந்து இல்லை; மாத்திரை இல்லை; தடுப்பூசியும் இல்லை. அதனால், கையில் இருக்கும் துணை மருந்துகளைத்தான் நம்ப வேண்டும். சில மருந்துகள் கைகொடுக்கின்றன; பல மருந்துகள் கைவிரிக்கின்றன. கரோனாவுக்குக் கைகொடுக்கும் மருந்தாக அண்மையில் ‘அடையாளம்’ காணப்பட்டிருக்கிறது, ஸ்டெம் செல்கள்!
முதலில் சீனாவிலும், பிறகு இஸ்ரேலிலும், இப்போது அமெரிக்காவிலும் கரோனா நோயாளிகளுக்கு ஸ்டெம் செல் சிகிச்சை (Stem cell therapy) ஆய்வு ரீதியில் கொடுக்கத் தொடங்கி விட்டனர். நோயின் இறுதிக் கட்டத்தில் வென்டிலேட்டர் சிகிச்சையில் இருந்த பல நோயாளிகள் குணமடைந்ததாக முதல் கட்ட ஆய்வுகள் கூறுகின்றன. அண்மையில் அறிமுகமான பிளாஸ்மா சிகிச்சை போல இனி ஸ்டெம் செல் சிகிச்சையையும் இவர்களுக்கு மேற்கொள்ளலாம் எனப் பல நாடுகள் துணிந்துள்ளன.
ஸ்டெம் செல் சிகிச்சை என்றால் என்ன?
சிகிச்சையைச் சொல்வதற்கு முன்னால் உங்களுக்கு ‘ஸ்டெம் செல்’லை அறிமுகப்படுத்தி விடுகிறேன். கருவுற்ற போது ஒற்றை செல்லாக ஆரம்பித்து முழு மனிதராக வளர்ந்த உடலில் ஏறத்தாழ 37 லட்சம் கோடி செல்கள் இருக்கின்றன. இத்தனையும் ஒரு செல்லில் இருந்து வந்தவைதான். அப்படியான ஒரு செல் வகைதான் ஸ்டெம் செல் என்பதும். உடலின் வளர்ச்சிக்கும் உயிரின் நீட்சிக்கும் அடிப்படையாகவும் ஆதாரமாகவும் உள்ள செல், ஸ்டெம் செல்.
ஒரு மரத்தின் தன்மை அதன் விதையில் பொதிந்து இருப்பதுபோல் மனித உடலின் தன்மை ஸ்டெம் செல்லில் இருக்கிறது. எப்படி மண்ணில் விழுந்த ஒரு விதை வேர், தண்டு, கிளை, இலை, பூ, காய், கனி எனப் பல அவதாரங்கள் எடுத்து மரமாக நிற்கிறதோ, அப்படித்தான் ஒரு ஸ்டெம் செல்லானது கை, கால், கண், காது, மூக்கு, பல், முதுகு, மூளை, இதயம், எலும்பு என வளர்ந்து முழு உடம்பாகி நுரையீரலுக்குள் நுழைந்து உயிர் தருகிறது.
நம் உடலில் கருத்தரித்த கருமுட்டை, ரத்தம், எலும்பு மஜ்ஜை, தொப்புள் கொடி, நச்சுக்கொடி (Placenta), தசை, தோல், கொழுப்புத் திசு, கல்லீரல், கணையம், மூளை போன்றவற்றில் ஸ்டெம் செல்கள் எப்போதும் இருக்கின்றன. இந்த செல்களைப் பிரித்து, ஒரு வளர் ஊடகத்தில் (Culture medium) வளர்த்து, நம் தேவைக்கேற்ப இதயம், நுரையீரல், கல்லீரல், எலும்பு, தோல், சிறுநீரகம், கணையம் என உடலின் எந்த ஓர் உறுப்பின் செல்களாகவும் மாற்றிக் கொள்ள முடியும். இவற்றின் எண்ணிக்கையைப் பெருக்கிக் கொள்ள முடியும். நவீன அறிவியல் கொடுத்துள்ள கொடை இது.
உடல் செல்களில் / திசுக்களில் குறைபாடு அல்லது நோய் ஏற்படும் போது, அங்கு ஸ்டெம் செல்களைப் புகுத்தி, புத்துயிர் ஊட்டி, மறுபடியும் பழைய நிலைக்குக் கொண்டு வரும் சிகிச்சை, ‘ஸ்டெம் செல் சிகிச்சை’. ஒரு கட்டிட விரிசலுக்குக் காரணமான செங்கல்லை எடுத்து விட்டு அந்த இடத்தில் புதுச் செங்கலை வைத்துப் பூசிவிட்டால் புதுச்சுவர் ஆகிவிடுகிறது அல்லவா? அதுபோல, உடலில் பழுதான உறுப்புகளைப் புதுப்பிக்கும் சிகிச்சை இது. பலதரப்பட்ட புற்றுநோய்களுக்கும் ரத்த, நரம்பு நோய்களுக்கும் பயன்படுகிற ‘ஸ்டெம் செல் சிகிச்சை’ கரோனாவை எப்படி சரிப்படுத்துகிறது?
‘சைட்டோகைன் சுனாமி’ தெரியுமா?
கரோனா பாதிப்பால் உடல் இழப்பது ஆக்ஸிஜன் செறிவு. அதற்கு பிரதானக் காரணம், நுரையீரல் நசிவு. இது ‘சைட்டோகைன் ஸ்டார்ம்’ (Cytokine storm) எனும் ‘சுனாமி’யின் விளைவு. பொதுவாக உடலுக்குள் கிருமிகள் நுழைந்ததும் நம் தடுப்பாற்றல் மண்டலம் அவசரகதியில் அவற்றை அழிப்பதற்கான முயற்சிகளை மேற்கொள்ளும். இன்டர்ஃபெரான், இன்டர்லுயூக்கின் போன்ற சைட்டோகைன் நோய்த் தடுப்புப் புரதங்களை ரத்தத்தில் அள்ளி வீசும். இவை ‘சூறாவளி’க்கு ஒப்பானவை. கிருமிகள் இந்தச் சூறாவளிச் சுழலில் சிக்கி இறந்துவிடும்.
ஆனால், கரோனாவைப் பொறுத்தவரை தடுப்பு மண்டலம் செய்யும் பெருந்தவறு, சைட்டோகைன் ‘சூறாவளி’க்குப் பதிலாக சைட்டோகைன் ‘சுனாமி’யை அனுப்பிவிடுவதுதான். இது ரத்தப் பயணத்தில் உடலெங்கும் புகுந்து கிருமிகளைச் சூறையாடுகிறது. அதேசமயம் கரோனா கிருமிகள் மட்டுமல்லாது ‘சுனாமி’ புகுந்த இடங்கள் எல்லாம் நாசமாகின்றன. முக்கியமாக, நுரையீரல் செல்கள் ரொம்பவும் நசிந்து போகின்றன. அங்கு நீர் கோர்த்துக் கொள்ள, பயனாளிக்கு ஆக்ஸிஜன் கிடைக்காமல் போகிறது. மூச்சு முட்டுகிறது. ரத்தம் நச்சாகிறது.
சைட்டோகைன் ‘சுனாமி’யைக் கட்டுப்படுத்த, இப்போது ‘டோஸிலிஜுமாப்’ (Tocilizumab) எனும் மருந்து தரப்படுகிறது. ஆனாலும் இதை மட்டுமே நம்ப முடியவில்லை. இதற்கு ஒரு மாற்று ஏற்பாடும் தேவைப்படுகிறது. அதுதான் ஸ்டெம் செல் சிகிச்சை!
உதவிக்கு வரும் ஸ்டெம் செல்கள்
பொதுவாக, நாட்டுக்குள் சுனாமி வந்துவிட்டால் நாம் என்ன செய்கிறோம்? சுனாமி சீரழித்த இடங்களையும் வீடுகளையும் சீர்திருத்துகிறோம், இல்லையா? அதுமாதிரியான ஒரு சீரமைப்புப் பணியைத்தான் ஸ்டெம் செல்கள் செய்கின்றன. அதற்கு கர்ப்பிணி பிரசவிக்கும் ‘பிளாசன்டா’ எனும் நச்சுக்கொடி உதவுகிறது. நச்சுக்கொடியில் அல்லது தொப்புள் கொடியில் உள்ள ‘மீசென்கைம்’ ஸ்டெம் செல்களைப் (Mesenchyme stem cells) பிரித்தெடுத்து, வளர்த்து, உடலுக்குள் எப்படி நடந்துகொள்ள வேண்டும் எனப் பாடம் நடத்தி (Programming), கரோனா நோயாளிகளுக்கு ஊசி மூலம் செலுத்துகிறார்கள். இவை உடனே வேலை செய்யாது; சுனாமிக்குப் பிறகு அது பாதித்த பகுதிகளை மந்திரிகள் பார்வையிடுவதைப்போல ரத்தம் மூலம் உடலெங்கும் பயணித்து, அங்கு ஏற்பட்டுள்ள பாதிப்பின் தீவிரத்தையும் அதை சரிப்படுத்த என்னவெல்லாம் தேவை என்பதையும் புரிந்துகொண்ட பிறகுதான் அடுத்த காரியத்தில் இறங்கும்.
இரண்டு வித புரதங்கள்
‘மீசென்கைம்’ ஸ்டெம் செல்லானது முதலில் 2 விதமான புரதங்களைச் சுரக்கிறது. முதலாவது புரதம் ‘சுனாமி’யைத் தூண்டும் புரதங்களை ஆறுதல்படுத்தி அடங்க வைக்கிறது. அடுத்த புரதமானது ஏற்கனவே ‘சுனாமி’யாகிவிட்ட புரதங்களின் மீது எதிர்தாக்குதல் செய்து காரியத்தைக் கைவிடச் செய்கிறது. இந்த வழியில் சைட்டோகைன் சுனாமி ‘கரையேறி’விடுகிறது. தடுப்பாற்றல் இயல்பு நிலைக்குத் திரும்புகிறது.
அடுத்த காரியமாக, உடலில் எங்கெல்லாம் செல்கள் சேதமாகி செயல் இழந்து செழிப்பில்லாமல் இருக்கிறதோ அங்கெல்லாம் அமினோ அமிலங்களைச் சுரந்து புதிய செல்களை புகுத்துகிறது. குறிப்பாக, சுனாமி பேயாட்டம் போட்ட நுரையீரல்களைப் புத்தம்புது செல்களால் புதுப்பிக்கிறது. ரத்த ஓட்டம் சீரடைகிறது. இதன் பலனால் அழிவின் விளிம்பில் இருக்கும் நுரையீரல்கூட ஆயுள் பெறுகிறது; அதைத் தொடர்ந்து நுரையீரல் ஆக்ஸிஜன் சப்ளையை ஆரம்பித்து விடுகிறது. இப்போது பயனாளியால் மூச்சுவிட முடிகிறது. உடலில் ஸ்டெம் செல்கள் மேற்கொள்ளும் பேரிடர் மீட்பின் சாதனை இது.
அமெரிக்காவில் அனுமதிக்கப்பட்ட ஸ்டெம் செல்களுக்கு ரெமிஸ்டெம்செல்-எல் (Remestemcel-L) என்று பெயர். இஸ்ரேல் பயன்படுத்தியது புளூரிஸ்டெம் (Pluristem) செல்கள். ஒரு நச்சுக்கொடியில் இருந்து பெறப்படும் ஸ்டெம் செல்களைக் கொண்டு 20,000 பேருக்கு சிகிச்சை கொடுக்க முடியும் என்கிறது இஸ்ரேல். அப்படியானால், கரோனா யுத்தத்தின் ‘கேம் சேஞ்சர்’ ஆகுமா, ஸ்டெம் செல் சிகிச்சை?
கரோனாவால் உலகிலேயே அதிக பாதிப்புக்கு ஆளாகியுள்ள அமெரிக்காவில் இதை மேற்கொள்வதற்கு FDA அனுமதி அளித்துவிட்டது. இனி, உலக நாடுகள் பலவும் இதை சிரமேற்கொள்ளும். அப்போது இதன் சாதக பாதகங்கள் தெரிய வரும். சாதகங்கள் அதிகம் என்றால் உலக சுகாதார நிறுவனம் அதை அங்கீகரிக்கும். அதன் பிறகுதான் ஸ்டெம் செல் சிகிச்சை பரவலாகும். அந்த நாள் எந்த நாள் என்பதை காலம்தான் பதில் சொல்லும். அதுவரை சமூக இடைவெளிதான் நம்மை கரோனாலிருந்து காப்பாற்றும். கைச்சுத்தம் கரோனாவைக் கட்டுக்குள் வைக்கும்.
கட்டுரையாளர், பொதுநல மருத்துவர்,